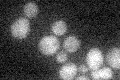
YNL009W
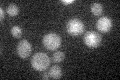
YNL009W

View description
Peroxisomal NADP-dependent isocitrate dehydrogenase, catalyzes oxidation of isocitrate to alpha-ketoglutarate with the formation of NADP(H+), required for growth on unsaturated fatty acids
Localization:
Intensity:
Fold change:
Significance:
-
C’ GFP library in SD
cytosol20.43 -
N' NOP1pr-GFP in SD

punctate90.1325 -
N' TEF2pr-mCherry in SD

punctate93.613 -
N' NATIVEpr-GFP in SD

punctate21.5617 -
N' TEF2pr-VC and Cyto-VN in SD

punctate29.9434 -
C’ GFP library in SD+DTT

cytosol21.71.06No -
C’ GFP library in SD+H2O2

cytosol19.960.97No -
C’ GFP library in Starvation Media
cytosol20.961.02No -
C’ GFP library on the background of Pup2-DaMP

cytosol -
C’ GFP library on the background of CCT mutant

cytosol19.8950.973496No
